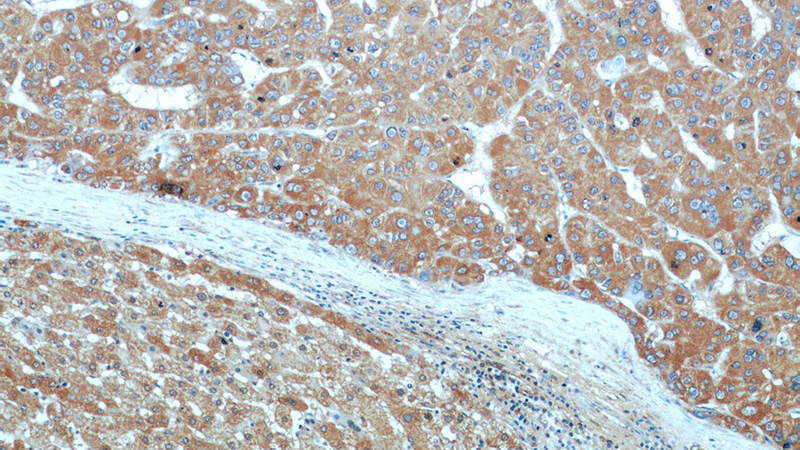
Immunohistochemical of paraffin-embedded human liver cancer using Catalog No:107912(AFP antibody) at dilution of 1:50 (under 10x lens)
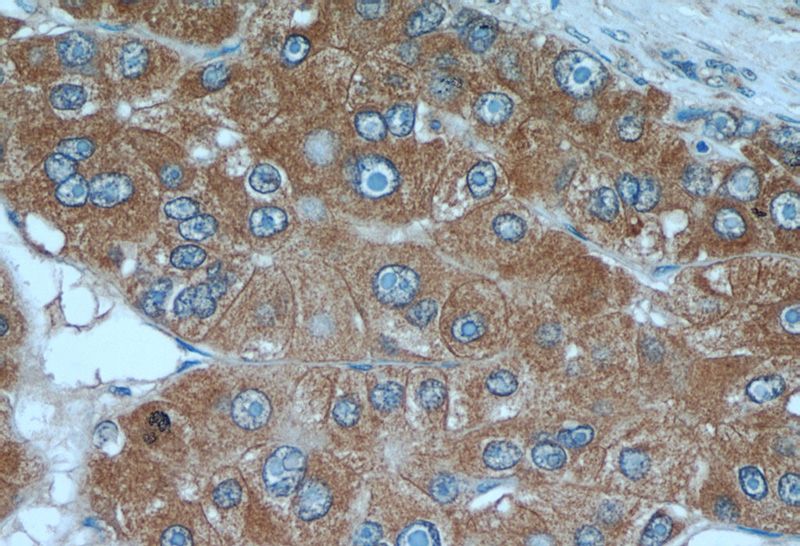
Immunohistochemical of paraffin-embedded human liver cancer using Catalog No:107912(AFP antibody) at dilution of 1:50 (under 40x lens)

-
Product Name
AFP antibody
- Documents
-
Description
AFP Rabbit Polyclonal antibody. Positive IP detected in HepG2 cells. Positive WB detected in human brain tissue, BxPC-3 cells, HepG2 cells, human heart tissue, rat brain tissue, SH-SY5Y cells, SW 1990 cells. Positive IHC detected in human liver cancer tissue, human ovary tumor tissue. Observed molecular weight by Western-blot: 68-72 kDa
-
Tested applications
ELISA, WB, IHC, IP
-
Species reactivity
Human,Mouse,Rat; other species not tested.
-
Alternative names
AFP antibody; Alpha 1 fetoprotein antibody; Alpha fetoglobulin antibody; alpha fetoprotein antibody; FETA antibody; HPAFP antibody
-
Isotype
Rabbit IgG
-
Preparation
This antibody was obtained by immunization of AFP recombinant protein (Accession Number: NM_001134). Purification method: Antigen affinity purified.
-
Clonality
Polyclonal
-
Formulation
PBS with 0.02% sodium azide and 50% glycerol pH 7.3.
-
Storage instructions
Store at -20℃. DO NOT ALIQUOT
-
Applications
Recommended Dilution:
WB: 1:1000-1:10000
IP: 1:500-1:5000
IHC: 1:20-1:200
-
Validations

human brain tissue were subjected to SDS PAGE followed by western blot with Catalog No:107912(AFP antibody) at dilution of 1:2000

IP Result of anti-AFP (IP:Catalog No:107912, 5ug; Detection:Catalog No:107912 1:1000) with HepG2 cells lysate 6000ug.
Immunohistochemical of paraffin-embedded human liver cancer using Catalog No:107912(AFP antibody) at dilution of 1:50 (under 10x lens)
Immunohistochemical of paraffin-embedded human liver cancer using Catalog No:107912(AFP antibody) at dilution of 1:50 (under 40x lens)
-
Background
AFP, also known as Alpha-fetoprotein, is a major plasma protein in the fetus and its concentration is very low in the adult. So AFP is usually considered a marker of hepatocyte precursors. AFP can be detected at abnormally high concentrations in hepatocellular carcinomas as well as in the plasma and ascitic fluid of adults with hepatoma. High AFP concentrations have been correlated with tumor cell growth, indicating that AFP can serve as a tumor marker.
-
References
- Ye S, Tan L, Yang R. Pleiotropy of glycogen synthase kinase-3 inhibition by CHIR99021 promotes self-renewal of embryonic stem cells from refractory mouse strains. PloS one. 7(4):e35892. 2012.
- Sone M, Nishikawa Y, Nagahama Y. Recovery of mature hepatocytic phenotype following bile ductular transdifferentiation of rat hepatocytes in vitro. The American journal of pathology. 181(6):2094-104. 2012.
- Zhou M, Zhao F, Li J. Long-term maintenance of human fetal hepatocytes and prolonged susceptibility to HBV infection by co-culture with non-parenchymal cells. Journal of virological methods. 195:185-93. 2014.
- Tsujiwaki M, Murata M, Takasawa A. Aberrant expression of claudin-4 and -7 in hepatocytes in the cirrhotic human liver. Medical molecular morphology. 48(1):33-43. 2015.
- Zhou M, Huang Y, Cheng Z. Revival, characterization, and hepatitis B virus infection of cryopreserved human fetal hepatocytes. Journal of virological methods. 207:29-37. 2014.
- Yang Y, Akinci E, Dutton JR, Banga A, Slack JM. Stage specific reprogramming of mouse embryo liver cells to a beta cell-like phenotype. Mechanisms of development. 130(11-12):602-12. 2013.
- Bertram K, Valcu CM, Weitnauer M, Linne U, Görlach A. NOX1 supports the metabolic remodeling of HepG2 cells. PloS one. 10(3):e0122002. 2015.
- Hou R, Wang YW, Liang HF. Animal and cellular models of hepatocellular carcinoma bone metastasis: establishment and characterisation. Journal of cancer research and clinical oncology. 141(11):1931-43. 2015.
Related Products / Services
Please note: All products are "FOR RESEARCH USE ONLY AND ARE NOT INTENDED FOR DIAGNOSTIC OR THERAPEUTIC USE"
